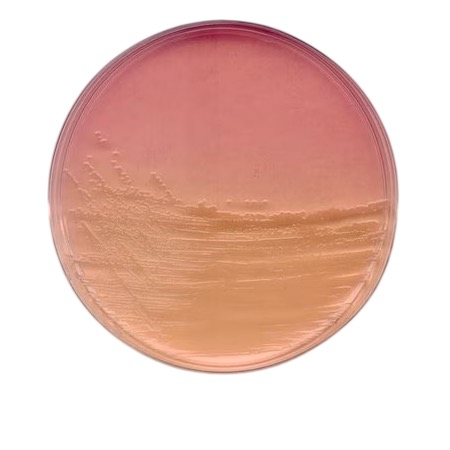
product

Spectroquant® Nitrate Test (catalogue 114776) enables reliable quantification of nitrate (NO₃-N) in aqueous samples using photometric methods. It is offered in two configurations: 335 tests and 1000 tests. Designed for use in environmental, water, food & beverage, and industrial applications, the test kit is compatible with Spectroquant® photometers and supports water quality monitoring and regulatory compliance.
The Spectroquant® Nitrate Test, catalogue number 114776 (1.14776), is a ready-to-use photometric reagent test kit supplied by MilliporeSigma / Merck for the quantification of nitrate in water and aqueous samples. The test is based on established colorimetric chemistry and is designed for use with compatible Spectroquant® photometers. Two kit sizes are available, providing 335 tests or 1000 tests, to match laboratory throughput and analytical needs.
Advantages
- Photometric determination of nitrate with ready-to-use reagents.
- Available in configurations for 335 tests and 1000 tests.
- Compatible with Spectroquant® photometers for consistent results.
- Suitable for water quality analysis in environmental, industrial and food & beverage applications.
Technical specifications
| Pack configurations | 335 tests; 1000 tests |
| Analyte | Nitrate (NO₃-N) |
| Method | Photometric (colorimetric) |
| Compatible instruments | Spectroquant® photometers (e.g., Move 100, Nova 60 A, Prove series) |
| Typical applications | Drinking water, surface water, wastewater, industrial water, food & beverage monitoring |
| Storage conditions | Store at 15–25 °C in a dry place |
| Brand | Merck |